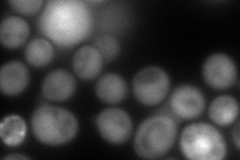
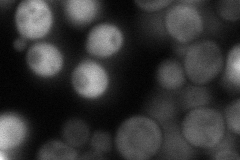
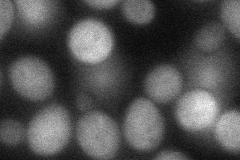

View description
Nonessential protein of unknown function; predicted to be involved in ribosome biogenesis; green fluorescent protein (GFP)-fusion protein localizes to the cytoplasm; similar to mammalian BRP16 (Brain protein 16)
Localization:
Intensity:
Fold change:
Significance:
-
C’ GFP library in SD

below threshold15.3 -
N' NOP1pr-GFP in SD

cytosol115.749 -
N' TEF2pr-mCherry in SD
cytosol154.023 -
N' NATIVEpr-GFP in SD
cytosol68.6436 -
N' TEF2pr-VC and Cyto-VN in SD
cytosol53.8474 -
C’ GFP library in SD+DTT

cytosol18.241.19No -
C’ GFP library in SD+H2O2

cytosol20.061.31No -
C’ GFP library in Starvation Media

cytosol27.421.79No -
C’ GFP library on the background of Pup2-DaMP

below threshold -
C’ GFP library on the background of CCT mutant

below threshold16.82851.0994No
